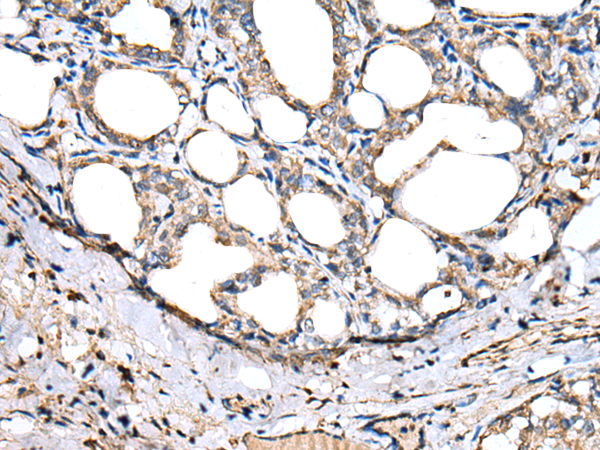

技術規(guī)格
|
Background: |
May play a role in the defense system against pathogens.Expressed only in the small intestine. |
|
Applications: |
ELISA, WB, IHC |
|
Name of antibody: |
ITLN2 |
|
Immunogen: |
Fusion protein of human ITLN2 |
|
Full name: |
intelectin 2 |
|
Synonyms: |
HL2; HL-2 |
|
SwissProt: |
Q8WWU7 |
|
ELISA Recommended dilution: |
5000-10000 |
|
IHC positive control: |
Human thyroid cancer |
|
IHC Recommend dilution: |
25-100 |
|
WB Predicted band size: |
36 kDa |
|
WB Positive control: |
Human ileum tissue lysate |
|
WB Recommended dilution: |
200-1000 |

購物車
幫助
021-54845833/15800441009
